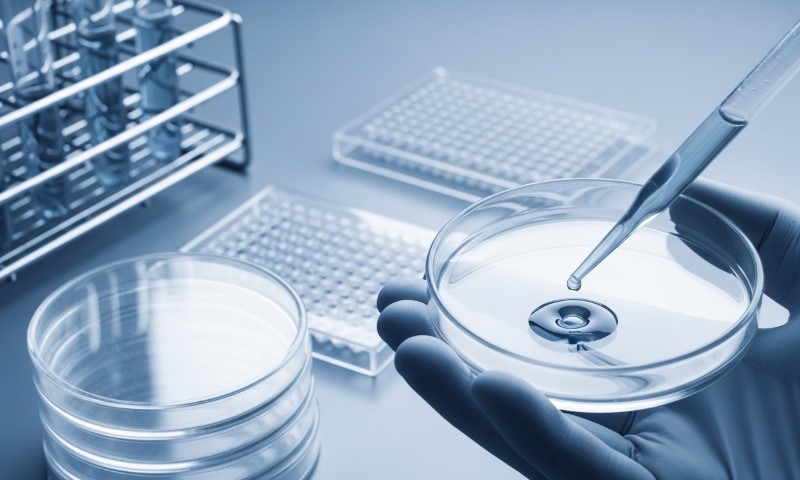

IVF has become a global market as much as a medical service. A patient in New York may face a bill that looks nothing like one in Prague, Barcelona, or Sydney, yet the headline number rarely tells the full story.
Lab methods, medication, funding rules, age limits, donor laws, and the way clinics report outcomes can change both the final bill and the real chance of taking home a baby.
For anyone comparing countries, two questions matter most: what a cycle really costs once add-ons and medication are counted, and what kind of success rate is being quoted.
Pregnancy per transfer, live birth per transfer, and cumulative live birth are not interchangeable. A low sticker price can become expensive after travel and extras.
A high quoted success rate can look less impressive once you check who was included in the data.
Why Country Comparisons Are Harder Than They Look

IVF data is not reported in one global format.
In the United States, the CDC and SART publish detailed clinic and national ART data.
In the United Kingdom, the HFEA provides national fertility figures and clinic statistics.
Cost comparisons are also messy because one clinic may quote only the procedure, while another folds in monitoring, ICSI, embryo freezing, or medication. Public funding changes the picture again.
England still advertises NHS eligibility rules of up to 3 full IVF cycles for eligible patients under 40, though local commissioning policies can vary.
British Columbia now offers eligible residents up to $19,000 toward one standard IVF cycle, and New South Wales offers a $2,000 fertility treatment rebate.
The Success Rate Problem
One clinic may advertise pregnancy rate per embryo transfer. Another may emphasize live birth rate. Another may highlight donor-egg outcomes, which are usually stronger than own-egg outcomes because donor age tends to be younger.
Age also changes everything. The HFEA reported a preliminary average fresh embryo transfer birth rate of 25% nationally in 2023 using a patient’s own eggs, but among patients aged 18 to 34 the figure was 35%, while patients aged 43 to 44 were at 5%.
CDC national summary data points in a similar direction on age pressure, though the agency reports across a different system and with different categories.
Nationally, 37.5% of ART cycles resulted in live-birth delivery in the latest CDC national summary page, but that broad figure covers a mix of patient ages, cycle types, and treatment paths.
A Snapshot of IVF Costs and Reported Outcomes
The table below combines national or registry-style success figures where available with representative private price points drawn from major clinic or official funding pages.
Numbers should be treated as planning benchmarks, not guaranteed totals.
United States: High Cost, Deep Data, Uneven Insurance
The United States offers some of the most detailed public fertility reporting in the world, but it is also one of the most expensive places to pay privately.
CDC national ART pages and SART tools give patients unusually rich clinic data, which helps when comparing outcomes. That level of transparency is a major advantage.
Cost is where many patients hit a wall. Even lower-cost providers such as CNY Fertility advertise IVF packages in the mid-$6,000 to low-$7,000 range, and broader U.S. market pricing often runs far higher once medication, anesthesia, genetic testing, embryo storage, and frozen transfer are added. Insurance mandates differ sharply by state, and many patients still face large out-of-pocket bills.
For a patient who values transparent public reporting and does not need to travel, the U.S. remains a strong option. For a self-pay patient without insurance coverage, total cost can be hard to stomach, especially if more than one retrieval is needed.
Who Usually Benefits Most From Staying in the U.S.
Patients with employer fertility coverage, access to mandated insurance benefits, or strong local clinic options often gain more by staying home than by chasing a lower sticker price abroad.
Local treatment reduces travel stress, makes repeat monitoring easier, and can simplify legal issues around donor gametes or embryo transport.
United Kingdom: Better Public Oversight, Mixed Access, Mid-Range Private Cost
@theipaper In every UK classroom, one child was born through IVF. IVF births have tripled since 2000, but access isn’t equal. Where you live and your ethnicity still shape your chances. Experts say it’s time for IVF to be fairer and faster for everyone. #IVF #fertility #NHS
The U.K. has one of the clearest fertility regulators in the HFEA. Patients can check clinic statistics, multiple birth data, and broader trends with more confidence than in many other markets.
HFEA figures for 2023 showed an average fresh embryo transfer birth rate of 25% nationally using a patient’s own eggs, rising to 35% for ages 18 to 34. Frozen transfer pregnancy and birth rates have also improved over time.
Private pricing sits below many U.S. quotes but well above some medical-tourism hubs. Care Fertility lists own-egg IVF from £4,950, while one lower-cost package is listed at £3,500. Yet even in the U.K., final bills rise with medication, ICSI, tests, freezing, or donor treatment.
NHS eligibility softens cost for some patients. NHS guidance says eligible patients aged 39 or under may get up to 3 full cycles, while eligible patients aged 40 to 42 may get 1 full cycle. On the ground, access can still depend on local policy and referral timing.
Why the U.K. Appeals to Cautious Patients
Strong regulation matters in fertility care. HFEA oversight gives patients a better chance to compare clinics on more than marketing copy. For anyone worried about misleading success claims, that structure has real value.
Canada: Strong Clinical Reputation, Funding Patchwork, Harder National Comparison
Canada is often seen as a middle ground between the U.S. and publicly supported systems elsewhere, yet the real experience depends heavily on province.
Ontario has expanded the Ontario Fertility Program, and British Columbia launched a publicly funded IVF program in 2025 that can provide up to $19,000 toward one standard cycle for eligible residents, with income thresholds affecting the amount.
Private pricing remains substantial. Trio Fertility lists a non-funded IVF cycle at $13,500 before medication, with medication running another $5,000 to $10,000 or more depending on protocol.
Mount Sinai Fertility fee pages show lower schedule figures for selected IVF cycle components, which illustrates how hard it can be to compare Canadian clinic prices without reading the fine print.
Canada’s main challenge for cross-country comparison is data visibility. Good clinics exist, but national consumer-facing outcome data is not as easy to pull into one clean benchmark as it is in the U.S. or U.K. A patient comparing Canada with Spain or Australia may need to lean more on clinic-level reporting and provincial policy.
Australia: High Retail Price, Strong Clinical Reputation, Rebates That Matter
Australia has a mature IVF sector and a reputation for high-quality clinical practice. Monash IVF’s public pricing page lists initial IVF cycle costs in New South Wales at $10,950 to $12,063, with additional costs possible depending on treatment path.
Medicare rebates and state support can reduce net cost, and NSW offers a $2,000 fertility treatment rebate for eligible patients.
Monash publishes age-specific 2023 clinical pregnancy and live birth results for fresh embryo transfers, which is useful because it lets patients see how age shifts the odds instead of staring at one flattering average.
Australia tends to appeal to patients who want a high-regulation English-speaking environment and can access rebates. For self-pay international patients, the country is less attractive as a bargain destination because travel and treatment costs stack up quickly.
Spain: A Major IVF Travel Hub With Strong Donor Access
Вижте тази публикация в Instagram.
Spain has become one of Europe’s best-known fertility destinations, especially for donor eggs and cross-border treatment. Legal access is broad for adult women, regardless of marital status or sexual orientation, and Spanish clinics have built an international patient pipeline around that openness.
Price is a major draw. Barcelona IVF has publicly referenced own-egg IVF at €4,970, and donor treatment pricing can still land below what many U.S. patients expect at home, though total cost depends on medication, travel, and whether more than one transfer is needed.
Success-rate comparison is trickier. A Spanish consensus document cited around a 30% chance of pregnancy after an IVF cycle for women under 35, dropping to about 10% for women aged 40 to 44. Numbers like that line up with the broad age story seen in other countries, but consumers need caution because not every Spanish source uses the same outcome measure or reporting standard.
Why Spain Often Looks Attractive on Paper
Spain works well for patients seeking donor treatment, shorter waiting times in some cases, and lower private prices than the U.S. or parts of the U.K. For own-egg IVF, value depends heavily on age and ovarian reserve. Cheap treatment loses appeal fast if multiple trips are needed.
Czech Republic: Lower Prices, Strong Tourism Appeal, Less Standardized Consumer Data
The Czech Republic is one of Europe’s most talked-about IVF destinations for self-pay patients.
Price lists and clinic materials from providers such as Gennet and Reprofit reinforce its lower-cost reputation, with procedure pricing often running below Western Europe and far below many U.S. clinics before add-ons are included.
Reported success can look excellent on clinic websites, but patients should read closely. Reprofit advertises success around 50% in some own-egg treatment contexts and higher cumulative figures in selected packages, but clinic claims are not the same as a neutral national benchmark.
Broader European reporting from ESHRE has put mean pregnancy rates per embryo transfer in Europe in the low 30% range for IVF and ICSI, though country and patient mix vary widely.
For budget-conscious patients willing to travel, the Czech Republic can make financial sense. For patients who want highly standardized public reporting, it may feel less straightforward than the U.K. or U.S.
What Actually Drives Cost Besides Country
Country matters, but the bill is shaped by several other factors:
- Medication: stimulation drugs can add thousands in North America and meaningfully lift totals in Europe too.
- ICSI, PGT-A, freezing, storage, and donor gametes: many headline prices exclude at least one of those items.
- Funding rules: public coverage, rebates, or tax credits can erase a large share of the gap between countries.
- Travel: flights, lodging, time off work, and repeat visits can wipe out the savings from a lower clinic quote.
How to Read IVF Success Claims Without Getting Burned

Before you compare clinic success claims, check what is actually being measured, who is included in the data, and whether the numbers reflect your age and treatment path.
Ask What Outcome Is Being Measured
Pregnancy is not the same as live birth. A clinic that quotes clinical pregnancy per transfer may sound stronger than one quoting live birth per started cycle, even when the second measure is more useful for a patient trying to estimate the real path to parenthood.
Check Age and Egg Source
A 32-year-old using her own eggs and a 42-year-old using donor eggs should never be folded into one feel-good headline. Age-specific reporting is far more useful. HFEA and many better clinic reports already break outcomes down that way.
Look for Single-Embryo Transfer Policy
Higher twin rates are not a sign of superior care. In many fertility systems, better practice has moved toward single-embryo transfer to reduce maternal and neonatal risk. The HFEA says the U.K. multiple birth rate in 2023 was under 4%.
Which Country Gives the Best Value?
No single country wins for every patient.
- The United States offers rich public data, but usually at the highest private cost.
- The United Kingdom combines strong oversight with more moderate private pricing and possible NHS help.
- Canada can work well for residents who qualify for provincial support, though national data is less easy to benchmark in one place.
- Australia offers reputable care, but out-of-pocket costs still run high without rebates.
- Spain and the Czech Republic often win on headline price for international patients, especially in donor or self-pay scenarios, though data comparability is weaker.
Final Take
The cheapest IVF country is not always the best-value IVF country. Good value comes from the mix of real net cost, reliable outcome reporting, legal fit, travel burden, and whether a clinic is quoting numbers that match your age and treatment path.
Anyone comparing countries should ask for a full fee schedule, check how success is measured, and treat glossy averages with caution.